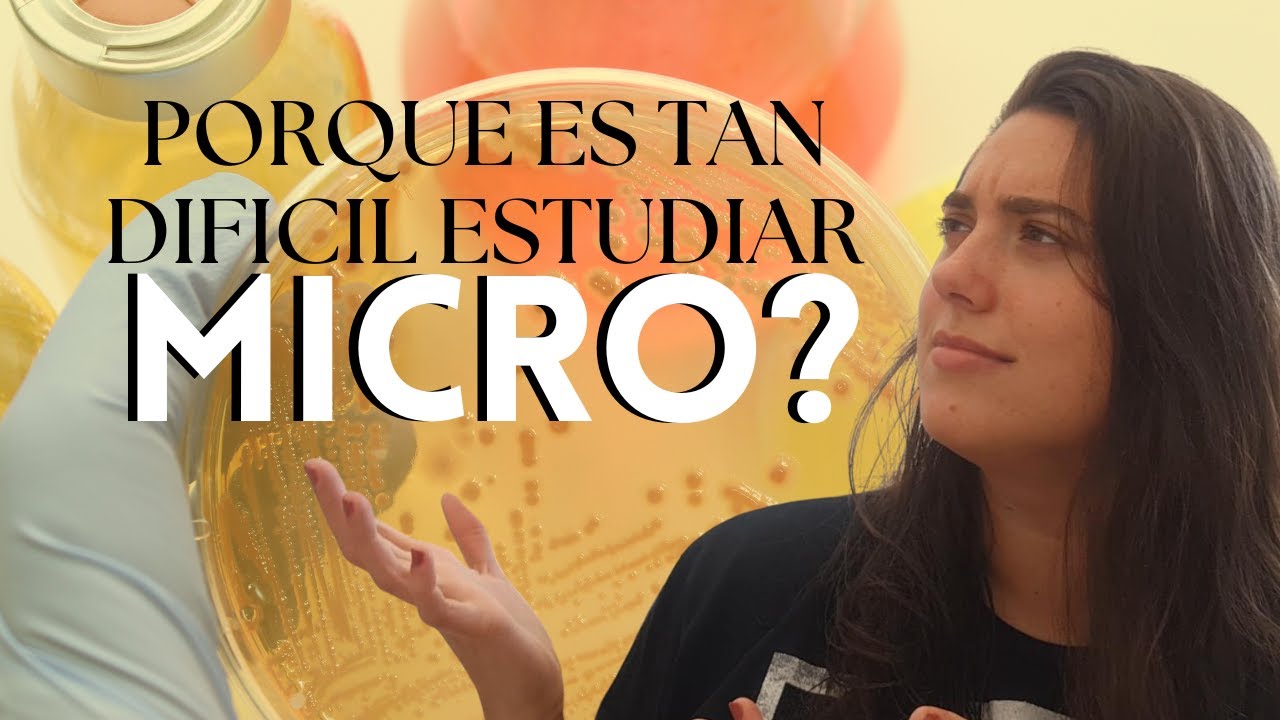
Como estudiar MICRO? | Porque es tan difícil estudiar microbiología? | MICRO CON LUA

QUE ES LA MICROBIOLOGIA | INTRODUCCION A MICROBIOLOGIA | MICRO CON LUA скачать в хорошем качестве
Повторяем попытку...

Скачать видео с ютуб по ссылке или смотреть без блокировок на сайте: QUE ES LA MICROBIOLOGIA | INTRODUCCION A MICROBIOLOGIA | MICRO CON LUA в качестве 4k
У нас вы можете посмотреть бесплатно QUE ES LA MICROBIOLOGIA | INTRODUCCION A MICROBIOLOGIA | MICRO CON LUA или скачать в максимальном доступном качестве, видео которое было загружено на ютуб. Для загрузки выберите вариант из формы ниже:
-
Информация по загрузке:
Скачать mp3 с ютуба отдельным файлом. Бесплатный рингтон QUE ES LA MICROBIOLOGIA | INTRODUCCION A MICROBIOLOGIA | MICRO CON LUA в формате MP3:
Если кнопки скачивания не
загрузились
НАЖМИТЕ ЗДЕСЬ или обновите страницу
Если возникают проблемы со скачиванием видео, пожалуйста напишите в поддержку по адресу внизу
страницы.
Спасибо за использование сервиса ClipSaver.ru
QUE ES LA MICROBIOLOGIA | INTRODUCCION A MICROBIOLOGIA | MICRO CON LUA
Hola, personas increibles de la internet! En este video de MICRO CON COFFEE, vamos hablar de que es la microbiologia, como materia y mas aun como rama de la biologia! Que estudiamos en micro, como estudiamos y que podemos esperar de nuestras cursadas? Apuntes: https://microbiologiaconlua.com.ar/ Hola, soy la Dra Lua! Soy medica UBA y por muchos años ayudante de MICROBIOLOGIA! Ahora me dedico a ayudar mas estudiantes a amar esta materia que aun que parezca dificil, si nos dedicamos es de las mas hermosas y abranguentes de la medicina! Por eso ademas de los videos que subo acá y en mi instagram @microconlua tambien doy cursos de microbiologia (Pensado para alumnoxs y medicos que necesitan aprender y AMAR la materia mas linda de la carrera de medicina Insta: @microconlua Grupo de micro en facebook: / 983224725065548 Grupo de dudas de whatsapp https://chat.whatsapp.com/FqPmCex87yO... Los apuntes: https://www.microbiologiaconlua.com.ar/